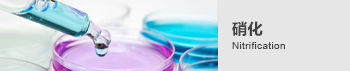

杭州創(chuàng)威實(shí)業(yè)股份有限公司是一家集科研、設(shè)計(jì)、生產(chǎn)、銷(xiāo)售、安裝、服務(wù)及氣體設(shè)備日常運(yùn)行管理為一體的高科技企業(yè),技術(shù)力量雄厚。主要產(chǎn)品有空氣分離設(shè)備、醫(yī)用分子篩制氧機(jī)、醫(yī)用中心供氧系統(tǒng)、醫(yī)用中心吸引系統(tǒng)、醫(yī)用小型制氧機(jī)、制氮機(jī)、壓力容器、壓力管道、空 氣凈化設(shè)備、高低壓氧艙、聲屏障、空氣源熱泵、環(huán)保污水處理設(shè)備等)。產(chǎn)品涵蓋國(guó)防、醫(yī)療、環(huán)保、石油、化工、高原環(huán)境、鐵路、航空、酒店等領(lǐng)域,公司擁有獨(dú)立進(jìn)出口權(quán),各類(lèi)資質(zhì)、證書(shū)齊全,并取得了幾十項(xiàng)國(guó)家專利技術(shù)。近年來(lái)承擔(dān)了國(guó)防、鐵路等領(lǐng)域眾多的科研任務(wù),并數(shù)次參加抗震救災(zāi)行動(dòng)。同時(shí)我公司是GB/T35414-2017《高原艙室內(nèi)彌散供氧(氧調(diào))要求》國(guó)家標(biāo)準(zhǔn)的起草和編制單位,也是QB/T5368-2019《家用制氧機(jī)》行業(yè)標(biāo)準(zhǔn)第一起草和編制單位......
杭州創(chuàng)威實(shí)業(yè)股份有限公司是一家集科研、設(shè)計(jì)、生產(chǎn)、銷(xiāo)售、安裝、服務(wù)及氣體設(shè)備日常運(yùn)行管理為一體的高科技企業(yè),技術(shù)力量雄厚。主要產(chǎn)品有空氣分離設(shè)備、醫(yī)用分子篩制氧機(jī)、醫(yī)用中心供氧系統(tǒng)、醫(yī)用中心吸引系統(tǒng)、醫(yī)用小型制氧機(jī)、制氮機(jī)、壓力容器、壓力管道、空 氣凈化設(shè)備、高低壓氧艙、聲屏障、空氣源熱泵、環(huán)保污水處理設(shè)備等)。產(chǎn)品涵蓋國(guó)防、醫(yī)療、環(huán)保、石油、化工、高原環(huán)境、鐵路、航空、酒店等領(lǐng)域,公司擁有獨(dú)立進(jìn)出口權(quán),各類(lèi)資質(zhì)、證書(shū)齊全,并取得了幾十項(xiàng)國(guó)家專利技術(shù)。近年來(lái)承擔(dān)了國(guó)防、鐵路等領(lǐng)域眾多的科研任務(wù),并數(shù)次參加抗震救災(zāi)行動(dòng)。同時(shí)我公司是GB/T35414-2017《高原艙室內(nèi)彌散供氧(氧調(diào))要求》國(guó)家標(biāo)準(zhǔn)的起草和編制單位,也是QB/T5368-2019《家用制氧機(jī)》行業(yè)標(biāo)準(zhǔn)第一起草和編制單位......

創(chuàng)威制氧機(jī)采用先進(jìn)的變壓吸附(Pressure Swing Adsorption簡(jiǎn)稱PSA)原理,以空氣為原材料,
通過(guò)物理方式分離出高純度的氧氣。產(chǎn)氧快,安全,經(jīng)濟(jì),方便。
輕巧取代瓶裝氧和化學(xué)制氧,是長(zhǎng)期用氧者的首選。



擁有獨(dú)立進(jìn)出口權(quán),各類(lèi)資質(zhì)、證書(shū)齊全,并取得多項(xiàng)國(guó)家專利技術(shù)。


大型供氧解決方案




老年人重度哮喘,慢性阻塞性肺炎,塵肺癥,工作傷害或疾病引起肺部纖維化和癌癥,造成呼吸困難,適合6升以下機(jī)種不夠用時(shí)使用
